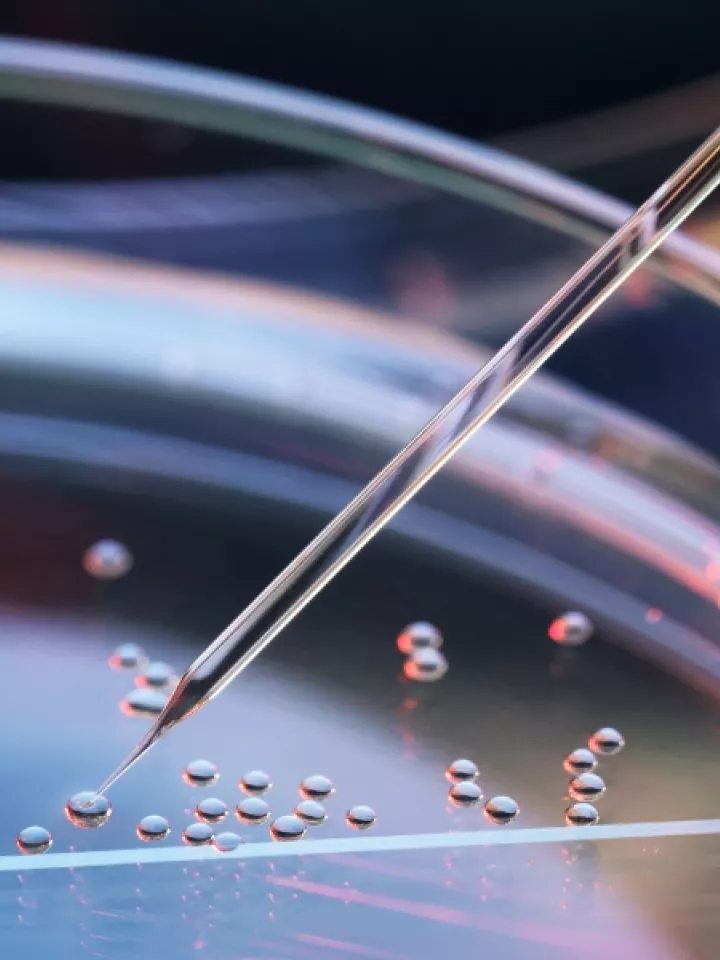
Graduate Program (PhD)

Overview
The Division of Dermatology at Albert Einstein College of Medicine is one of the nation’s leading academic dermatology programs with a distinguished history of excellence in research, clinical care, and education. We provide world-class care to patients with a wide array of dermatologic diseases and skin cancers.
Recent Publications
-
A case of eruptive keratoacanthomas and lichen planus secondary to nivolumab treatment for stage IV melanoma
Description: No abstract
Published: Thursday, February 13, 2025 -
Dual immunomodulator therapy with adalimumab and upadacitinib to treat recalcitrant hidradenitis suppurativa
Description: No abstract
Published: Monday, January 27, 2025 -
Large Nevus Lipomatosus Cutaneous Superficialis in the Skin of Color
Description: A 15-year-old African-American man (Fitzpatrick skin type V) presented to the outpatient dermatology clinic with a large, verrucous, exophytic mass measuring 3.5 × 2.3 cm on the right lateral side of the posterior flank (Figure 1). The lesion had been increasing in size for several years. His mother had refused a shave excision when he was 9 years old. He also had atopic dermatitis, acanthosis nigricans, and benign melanocytic nevi. He was obese with borderline hypercholesterolemia.
Published: Friday, January 3, 2025 -
Clinical characteristics of iatrogenic versus idiopathic linear IgA bullous dermatosis: A systematic review
Description: No abstract
Published: Wednesday, November 13, 2024 -
Papulonecrotic lesions and fever in an adult patient
Description: No abstract
Published: Monday, November 4, 2024
Contact Us
-
Department of Medicine, Division of Dermatology
Jack and Pearl Resnick Campus
1300 Morris Park Avenue
Bronx, NY 10461 -
Physicians and Patients
866-MED-TALK (866-633-8255)